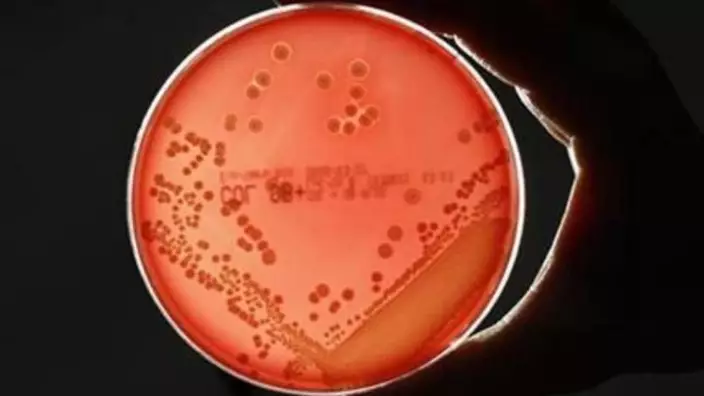

Scientists in Switzerland have discovered for the first time that bacteria, though without sensory organs, also have a sense of touch that enables them to recognize surfaces and respond to mechanical stimulus, University of Basel said Saturday.

By studying a bacterium called Caulobacter, a team from the university discovered that the tiny microorganism not only responds to chemical signals, but also recognizes surfaces and responds within seconds, a mechanism that is also used by pathogens to colonize and attack their host cells, said a press release from the university.
The team found that swimming Caulobacter has a whip-like rotating motor in their cell envelope called the flagellum. The rotation of the flagellum enables the bacteria to move in liquids. To the surprise of the researchers, the motor is also used as an organ for the bacteria to "feel."

Swimming bacteria can sense surfaces with the flagellum. /University of Basel Photo
The motor rotation is powered by proton flow into the cell via ion channels. When swimming cells touch surfaces, the motor is disturbed and the proton flux interrupted. It signals to the bacteria to produce an adhesive substance that firmly anchors the bacteria on the surface within a few seconds.
"Even though Caulobacter is a harmless environmental bacterium, our findings are highly relevant for the understanding of infectious diseases. What we discovered in Caulobacter also applies to important human pathogens," said team leader Prof. Urs Jenal of the University of Basel.
The team's study has been published on the Oct. 27 issue of the journal Science.
NEW YORK (AP) — Infection rates from drug-resistant “nightmare bacteria” rose almost 70% between 2019 and 2023, according to a new report from Centers for Disease Control and Prevention scientists.
Bacteria that are difficult to treat due to the so-called NDM gene primarily drove the increase, CDC researchers wrote in an article published Monday in the Annals of Internal Medicine. Only two antibiotics work against those infections, and the drugs are expensive and must be administered through an IV, researchers said.
Bacteria with the gene were once considered exotic, linked to a small number of patients who received medical care overseas. Though the numbers are still small, the rate of U.S. cases jumped more than fivefold in recent years, the researchers reported.
“The rise of NDMs in the U.S. is a grave danger and very worrisome,” said David Weiss, an Emory University infectious diseases researcher, in an email.
It's likely many people are unrecognized carriers of the drug-resistant bacteria, which could lead to community spread, the CDC scientists said.
That may play out in doctors’ offices across the country, as infections long considered routine — like urinary tract infections — could become harder to treat, said Dr. Maroya Walters, one of the report’s authors.
Antimicrobial resistance occurs when germs such as bacteria and fungi gain the power to fight off the drugs designed to kill them. The misuse of antibiotics was a big reason for the rise — unfinished or unnecessary prescriptions that didn’t kill the germs made them stronger.
In recent years, the CDC has drawn attention to “ nightmare bacteria ” resistant to a wide range of antibiotics. That includes carbapenems, a class of antibiotics considered a last resort for treatment of serious infections.
Researchers drew data from 29 states that do the necessary testing and reporting of carbapenem-resistant bacteria.
They counted 4,341 cases of carbapenem-resistant bacterial infections from those states in 2023, with 1,831 of them the NDM variety. The researchers did not say how many of the infected people died.
The rate of carbapenem-resistant infections rose from just under 2 per 100,000 people in 2019 to more than 3 per 100,000 in 2023 — an increase of 69%. But the rate of NDM cases rose from around 0.25 to about 1.35 — an increase of 460%, the authors said.
A researcher not involved in the study said the increase is probably related to the COVID-19 pandemic.
“We know that there was a huge surge in antibiotic use during the pandemic, so this likely is reflected in increasing drug resistance,” said Dr. Jason Burnham, a Washington University researcher, in an email.
The CDC’s count is only a partial picture.
Many states are not fully testing and reporting cases. Even in states that do, cases tend to be among hospital patients sick enough to warrant special testing. Many hospitals also aren’t able to do the testing needed to detect certain forms of genetic resistance.
The CDC researchers did not have data from some of the most populous states, including California, Florida, New York and Texas, which means the absolute number of U.S. infections “is definitely underestimated,” Burnham said.
This is not the first study to report a rise. A CDC report published in June noted an increase in NDM cases in New York City between 2019 and 2024.
This story was first published Sept. 23, 2025. It was updated Sept. 24, 2025, to make clear that Walters said routine infections could become harder to treat rather than become a chronic problem.
The Associated Press Health and Science Department receives support from the Howard Hughes Medical Institute’s Department of Science Education and the Robert Wood Johnson Foundation. The AP is solely responsible for all content.

This 2019 illustration provided by the Centers for Disease Control and Prevention depicts carbapenem-resistant Enterobacteriaceae (CRE) bacteria. (Stephanie Rossow/CDC via AP)

FILE - A sign marks the entrance to the U.S. Centers for Disease Control and Prevention headquarters Aug. 27, 2025, in Atlanta. (AP Photo/Brynn Anderson, File)